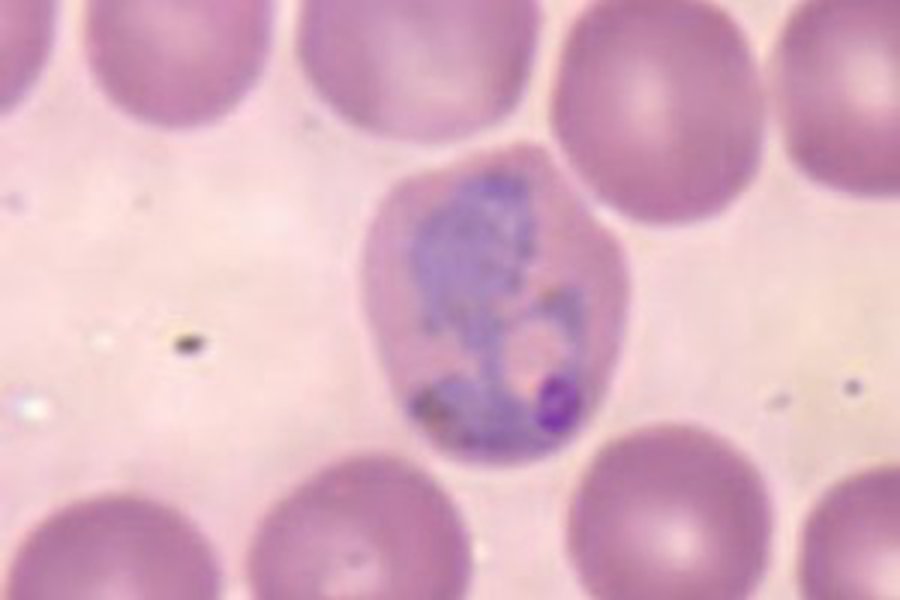
В Литве появилась малярия - Наука и здоровье

У жителя Каунасского района Литвы, который в начале августа побывал в Гане, обнаружена малярия, сообщил Каунасский центр общественного здоровья.:::По данным центра, 28-летний житель Каунасского района находился в Африке 3-11 августа.
Малярию распространяют малярийные комары, в организме которых созревают возбудители болезни — паразитические простейшие » плазмодии.
Если не лечить малярию, то она может привести к серьезным последствиям.
По данным центра, в мире ежегодно около 10 тыс. путешественников, вернувшихся из поездок, заболевают малярией, и около 1% заразившихся этой «болотной лихорадкой», умирает.
Что касается истории малярии, то есть предположение, что люди болеют малярией уже в течение 50 000 лет. Считается, что родиной малярии является Западная Африка (P. falciparum) и Центральная Африка (P. vivax). Молекулярно-генетические данные свидетельствуют, что предпаразитический предок плазмодия был свободноживущим простейшим, способным к фотосинтезу, который приспособился жить в кишечнике водных беспозвоночных. Также он мог жить в личинках первых кровососущих насекомых отряда Diptera, которые появились 150—200 миллионов лет назад, быстро приобретя возможность иметь двух хозяев. С появлением человека развились малярийные паразиты, способные к смене хозяина между человеком и комарами рода Anopheles. Древнейшие найденные окаменелости комаров с остатками малярийных паразитов имеют возраст 30 миллионов лет.
Первые летописные свидетельства лихорадки, вызванной малярией, были обнаружены в Китае. Они датируются приблизительно 2700 годом до н. э., временем правления династии Ся.
РуНет
В Литве появилась малярия
Комментарии
Для комментирования необходимо войти в аккаунт Facebook (Meta)
Наука и здоровье
другие новости раздела →
VMVT напоминает: с началом активного сезона клещей позаботьтесь о защите животных

Психосоциальную реабилитацию зависимым могут оказывать только лицензированные учреждения

Помело - крупный цитрус с мягким вкусом и пользой для здоровья

Мифы о здоровом питании: что подтверждено наукой, а что нет

Почему мандарины дарят ощущение новогодних праздников?

Может ли черный шоколад защищать от кариеса?

Осень на тарелке: чем полезна тыква и почему стоит добавить её в рацион
